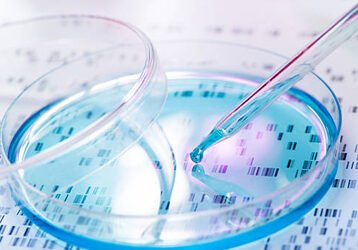

Our Products Are Used In
Welcome To Yaadvi Enterprises
We “Yaadvi Enterprises” founded in the year 2007 are a renowned firm that is engaged in Manufacturing and Exporting a wide assortment of Glass Droppers, Tubular Vials & all type of Laboratory Glassware & Equipment. We have a wide and well functional infrastructural unit. And helps in making a remarkable collection of products as per the global set standards. We export these products to UK, USA, Iran, Indonesia and Malaysia. We are a notable and prominent company that is managed under the headship of “Mr. Karan Kapoor (Director) and have achieved a significant position in this sector.
Yaadvi Enterprises is growing manufacturer of glass primary packaging – especially tubular glass vials (USP type-I) for pharmaceticals, diagnostic vials, chromatography glass consumables and glass vials/bottles for perfumes and cosmetics. Yaadvi name reveals ‘authority and power’ – glass primary packaging. We are most trusted brand for more 50 pharmaceuticals and diagnostic companies in India companies in India since 2007.
Our Production Facilities
Glass Tooling Department
Our Glass Tooling Department specializes in the precision manufacturing of high-quality glass instruments tailored for clinical applications. With advanced technology and skilled craftsmanship, we ensure accuracy and reliability in every piece to support superior patient care.
Lamp working Department
Our Lamp Working Department excels in crafting custom glass components through precise flame-working techniques. Our skilled artisans create durable, high-quality glassware essential for various clinical applications.
Lathe Department
Our Lathe Department is dedicated to producing precise and reliable glass components using advanced lathe machinery. With a focus on accuracy and quality, we ensure each piece meets the stringent standards required for clinical applications.
Grinding Department
Our Grinding Department specializes in the precision grinding of glass components, ensuring exact dimensions and smooth finishes. With advanced equipment and expert technicians, we deliver high-quality products essential for clinical precision.
Calibration Laboratory
Our Calibration Laboratory ensures the highest accuracy and reliability of clinical instruments through meticulous calibration processes. Utilizing state-of-the-art equipment, we guarantee precision and compliance with industry standards.
QUALITY, VALUE & CONVENIENCE AS OUR MOTO
Commitment to Quality
In the last few years of our service to the Pharma community, we've learned that the collaborative effort to design and manufacture a product to meet the customer's particular need builds a strong bond that fosters the trust that Yaadvi Enterprises currently enjoys with so many of you.
Streamlined Processes for Convenience
We simplify complex processes through efficient workflows and user-friendly solutions, making it easy for healthcare professionals to access and utilize our products and services.
300+ Clients are Served
Around the World
STRIVING FOR EXCELLENCE IN EVERYTHING WE DO
We will be present in every laboratory around the world and will accelerate scientific progress by providing a full range of products and solutions for customers in drug discovery, life science and industrial markets.
We earn the trust of our
customers
by facilitating improvements in their processes and enabling better results.
We empower our people to pursue ambitious goals
by constantly improving our products and processes.
We encourage creativity & innovation
so we can offer our customers new and better solutions for their needs.
We strive for excellence in everything we do.
With our technical and professional expertise, we have been able to fetch huge client base across the nation.